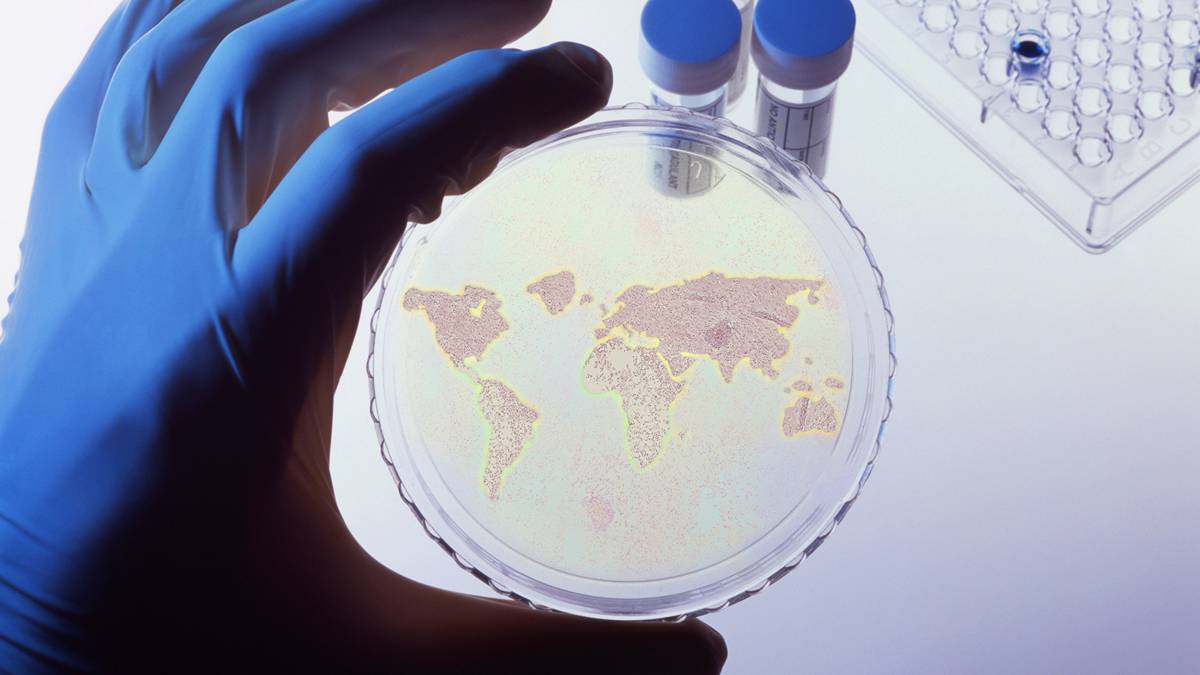
Culture plates AI

Who made the gains in October? Here are the top ASX resources winners
From petri dishes to pharma giants, Clever Culture’s AI goes global
Health Food Symmetry eyes public debut with $2 million raise to shake up gut health market
Closing Bell: ASX fends off losses in resources and tech with defensive rotation
Resources Top 5: Mont Royal makes strong return to the boards after landing Canadian rare earths play
Health Check: Our flu recovery prognosis is positive, CSL tells investors
Top cyber scientist warns of quantum computing security threats
Biocurious: Buoyed by capital raisings, biotechs storm home with a wet sail
Lunch Wrap: Rare earths tumble and tech rattled as the Big Short returns
Silver tsunami wave captures 700,000 retirees in super tax trap
Contributors
Our Resident Experts